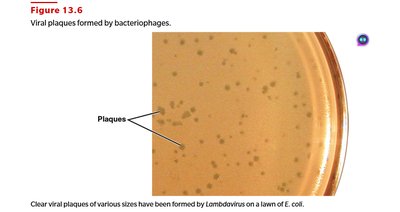
Viral plaques formed by bacteriophages

BackViruses, Viroids, and Prions: Structure, Classification, and Replication
Study Guide - Smart Notes
Tailored notes based on your materials, expanded with key definitions, examples, and context.
Viruses: Structure, Classification, and Replication
What is a Virus?
Viruses are unique infectious agents that differ fundamentally from bacteria and other microorganisms. They are considered non-living outside a host but exhibit characteristics of life when inside host cells, where they utilize host machinery for replication.
Obligate intracellular parasites: Require living host cells to multiply.
Size: Much smaller than most bacteria.
Genetic material: Contain either DNA or RNA, never both.
Structure: Surrounded by a protein coat (capsid), sometimes enclosed by an envelope of lipids, proteins, and carbohydrates.
No metabolic enzymes: Rely entirely on host cell enzymes for metabolism.
Host range: The spectrum of host cells a virus can infect is determined by specific interactions between viral surface proteins and host cell receptors. Viruses can infect animals, plants, fungi, protists, and bacteria (bacteriophages).
Structure of Viruses
Viruses are classified based on their morphology and the presence or absence of an envelope.
Virion: A complete, fully developed, infectious viral particle outside a host cell.
Capsid: Protein coat composed of subunits called capsomeres, protecting the nucleic acid.
Envelope: Some viruses have an outer lipid, protein, and carbohydrate envelope; others are nonenveloped.
Spikes: Some viruses have surface projections (spikes) for attachment to host cells.
General Virus Morphologies
Helical viruses: Cylindrical capsid with nucleic acid inside (e.g., rabies, Ebola).
Polyhedral viruses: Many-sided, often icosahedral (e.g., poliovirus).
Enveloped viruses: Spherical with an envelope (e.g., SARS-CoV-2).
Complex viruses: Capsids with additional structures (e.g., bacteriophages, poxvirus).

Viral Species
A viral species is a group of viruses sharing the same genetic information and ecological niche (host range and tissue specificity).
Virus Cultivation and Identification
Culturing Bacteriophages
Bacteriophages are commonly cultured using the plaque method:
Mix bacteriophage sample with host bacteria and melted agar.
Pour onto a Petri plate with a hardened agar base.
After incubation, clear zones called plaques appear where viruses have lysed bacteria.
Each plaque corresponds to a single virus in the initial sample (plaque-forming unit).
Culturing Animal Viruses
Living animals: Used to study immune responses and isolate viruses.
Embryonated eggs: Viral suspension injected into fertilized eggs; growth detected by embryo death or lesions.
Cell cultures: Animal cells grown in culture media; can be primary, diploid, or continuous cell lines.
Continuous cell lines (often cancerous) can be maintained indefinitely and are widely used for virus cultivation.
Virus Identification Techniques
ELISA: Detects viral antigens using antibodies.
Cytopathic effects: Observing changes in host cells due to viral infection.
PCR: Detects and amplifies viral nucleic acids.
Viral Replication Cycles
Lytic Cycle of Bacteriophages
The lytic cycle results in the destruction of the host cell and release of new virions. The main steps are:
Attachment: Phage attaches to host cell.
Penetration: Phage injects its DNA into the host.
Biosynthesis: Viral components are synthesized using host machinery.
Maturation: Assembly of viral particles.
Release: Host cell lyses, releasing new phages.

Lysogenic Cycle of Bacteriophage Lambda
In the lysogenic cycle, the phage DNA integrates into the host genome and replicates along with it, without killing the host immediately.
Prophage: Integrated phage DNA in the host chromosome.
Lysogeny: Phage remains latent; host cell survives and divides.
Excision: Prophage may exit the host genome, initiating the lytic cycle.
Consequences: Lysogenic cells are immune to reinfection by the same phage, may acquire new properties (phage conversion), and can transfer genes via specialized transduction.

Comparison: Bacteriophage vs. Animal Virus Multiplication
Stage | Bacteriophages | Animal Viruses |
|---|---|---|
Attachment | Tail fibers attach to cell wall proteins | Receptor sites are plasma membrane proteins and glycoproteins |
Entry | Viral DNA is injected into host cell | Capsid enters by receptor-mediated endocytosis or fusion |
Uncoating | Not required | Enzymatic removal of capsid proteins |
Biosynthesis | In cytoplasm | In nucleus (DNA viruses) or cytoplasm (RNA viruses) |
Chronic infection | Lysogeny | Latency, slow viral infections, cancer |
Release | Host cell is lysed | Enveloped viruses bud out; nonenveloped viruses rupture plasma membrane |

Replication of DNA-Containing Animal Viruses
Animal viruses generally follow these steps: attachment, entry, uncoating, biosynthesis, maturation, and release. DNA viruses typically replicate in the nucleus, while RNA viruses replicate in the cytoplasm.

Biosynthesis of DNA and RNA Viruses Compared
Baltimore Group | Viral Nucleic Acid | Virus Family | Special Features of Biosynthesis |
|---|---|---|---|
I | DNA, double-stranded | Herpesviridae, Papovaviridae | Cellular enzyme transcribes viral DNA in nucleus |
II | DNA, single-stranded | Parvoviridae | Cellular enzyme transcribes viral DNA in nucleus |
III | RNA, double-stranded | Reoviridae | Viral enzyme transcribes viral RNA in cytoplasm |
IV | RNA, + strand | Picornaviridae, Coronaviridae | Viral RNA functions as mRNA for synthesis of RNA polymerase and viral proteins |
V | RNA, - strand | Rhabdoviridae | Viral enzyme copies viral RNA to make mRNA in cytoplasm |
VI | RNA, reverse transcriptase | Retroviridae | Viral enzyme copies viral RNA to make DNA in cytoplasm; DNA moves to nucleus |
VII | DNA, reverse transcriptase | Hepadnaviridae | Cellular enzyme copies viral DNA in nucleus; reverse transcriptase copies mRNA to make viral DNA |

Latent and Persistent Viral Infections
Latent Viral Infections
Latent infections are characterized by periods of inactivity, with the virus remaining in equilibrium with the host and not producing disease unless reactivated by stimuli or immune changes.
Examples: Herpes simplex virus (cold sores), Varicella-zoster virus (shingles).
Persistent Viral Infections
Persistent infections involve a continuous, often fatal, increase in detectable virions over time. The virus is continuously released and may cause progressive disease.
Examples: HIV/AIDS, liver cancer (hepatitis B/C), progressive encephalitis (measles virus).
Disease | Primary Effect | Causative Virus |
|---|---|---|
Cold sores (latent) | Skin and mucous membrane lesions; genital lesions | HSV-1 and HSV-2 |
Leukemia (latent) | Increased white blood cell growth | HTLV-1 and 2 |
Shingles (latent) | Skin lesions | Varicella-zoster virus |
Cervical cancer (persistent) | Viruses continuously released; increased cell growth | Human papillomavirus |
HIV/AIDS (persistent) | Decreased CD4+ T cells | HIV-1 and 2 |
Liver cancer (persistent) | Increased cell growth | Hepatitis B virus |
Progressive encephalitis (persistent) | Rapid mental deterioration | Rubella virus |
Subacute sclerosing panencephalitis (persistent) | Mental deterioration | Measles virus |

Viroids, Prions, and Oncogenic Viruses
Viroids
Viroids are infectious agents composed solely of short, circular, single-stranded RNA molecules without a protein coat. They cause diseases in plants by gene silencing and are resistant to enzymatic degradation due to their folded structure.
Example: Potato spindle tuber viroid.
Prions
Prions are infectious proteins that cause neurodegenerative diseases in animals and humans. They lack nucleic acids and induce abnormal folding of normal cellular proteins, leading to brain damage.
Examples: Kuru, Creutzfeldt-Jakob disease, fatal familial insomnia.
Viruses
Viruses are infectious agents with nucleic acid (DNA or RNA) enclosed in a protein coat, capable of infecting all life forms.
How Can a Protein Be Infectious?
Prions cause disease by inducing abnormal folding of normal proteins (PrPc to PrPsc), leading to aggregation and degeneration of brain tissue.
Oncogenic Viruses
Oncogenic viruses can induce cancer in host cells by integrating their genetic material into the host genome, disrupting normal cell regulation.
Example: Hepatitis B virus (liver cancer), human papillomavirus (cervical cancer).
